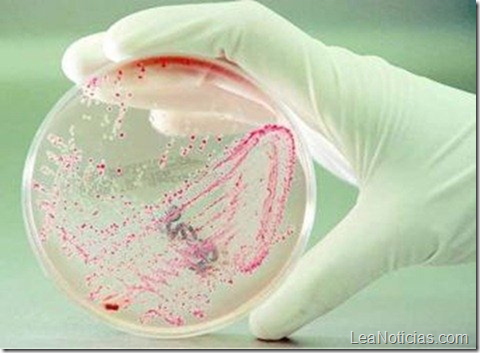
image

nvestigadores mexicanos del Centro de Investigación y de Estudios Avanzados (Cinvestav) pretenden sustituir los actuales microcircuitos de silicio en los sistemas computacionales por bacterias.
Según los investigadores predicen que las biocomputadoras serán el futuro, en las cuales la información no se transmitirá por impulsos eléctricos, sino mediante mensajes químicos. Estos inicios de la biocomputacion en México se están desarrollando a partir de la creación de osciladores biológicos, o sea sistemas biológicos que mandan señales en determinados lapsos de tiempo.
“La idea general de nuestro proyecto es obtener y cultivar bacterias que al recibir una señal química, liberen una sustancia, una proteína por ejemplo, en ciclos determinados”, explicó Eduardo Santillán, investigador del Departamento de Matemáticas del organismo del Instituto Politécnico Nacional (IPN).
Este avance se basa principalmente en introducir mediante una modificación genética un sistema de “on y off” en el microorganismo, pues estos no lo poseen de manera natural ya que “nunca duermen, ni descansan, ni se detienen”. Pero para esto se tiene que desarrollar un modelo matemático adecuado en el que muestren las oscilaciones deseadas, ni demasiado rápidas ni demasiado lentas.
Asi es como el futuro esta acercandose una vez mas, un futuro en el que los equipos de computo estarán interconectados con sistemas biológicos, aumentando las posibilidades de interfaces hombre-maquina.
[Fuente]
